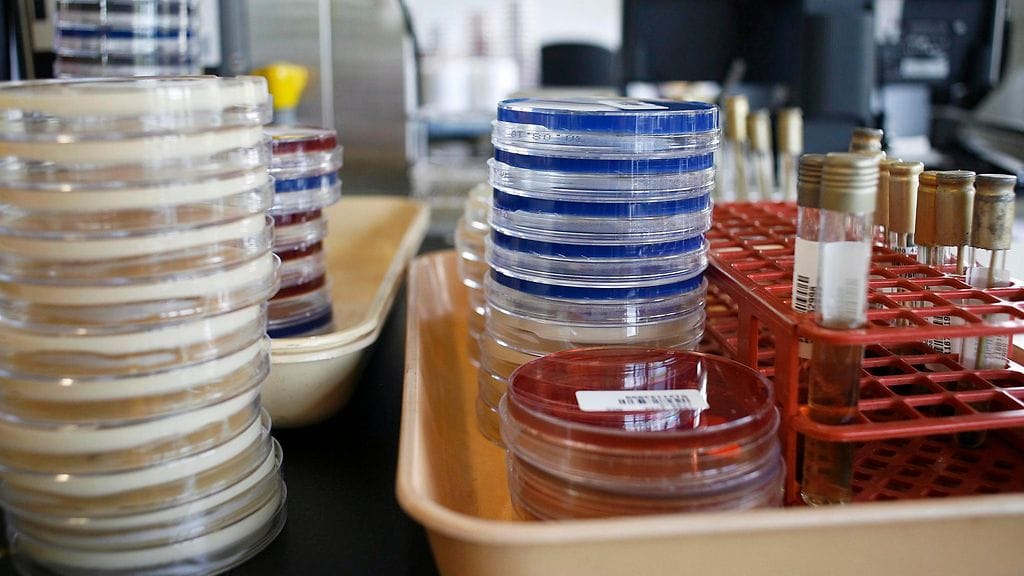

Yhdysvaltojen Nevadassa iäkäs nainen on kuollut superbakteeriin, johon ei tehonnut mikään Yhdysvalloissa saatavilla ollut antibiootti, kertovat useat uutissivustot, muun muassa The Telegraph.
Tartuntatautien kontrolli- ja ehkäisykeskus CDC julkaisi tapauksesta raportin torstaina. 70-vuotias nainen on kuollut jo syyskuussa, mutta raportti julkaistiin vasta nyt. Nainen oli saanut ainakin 26 eri antibioottia tuloksetta.
Nainen oli palannut Intiasta, jossa oli murtanut jalkansa. Yhdysvalloissa hän hakeutui hoitoon tulehduksien takia. Raportin mukaan elokuuhun mennessä naiseen oli kokeiltu useita eri antibiootteja ilman toivottua tulosta.
CDC toteaa raportissaan, että antibioottiresistenssiin bakteeriin ei ollut olemassa olevaa lääkettä.
– Mielestäni se on hyvin huolestuttavaa. Olemme luottaneet niin kauan vain antibiootteihin ja uusiin antibiootteihin. Ilmeisestikin bakteerit voivat kuitenkin kehittää vastustuskykyä nopeammin kuin me ehdimme tehdä uusia, toteaa raportin kirjoittanut lääkäri Alexander Kallen.
Superbakteerista on selvitetty, että sisältää New Delhi metallo-beetalaktamaasia, eli entsyymiä, joka tekee bakteerista vastustuskykyisen useille antibiooteille. Bakteerille on annettu nimi mcr-1 ja sitä pidetään hyvin tarttuvana.
Telegraphin mukaan Yhdysvalloista löytyi viime vuonna ainakin neljä potilasta, joilla oli antibiooteille vastustuskykyinen bakteeri elimistössään.